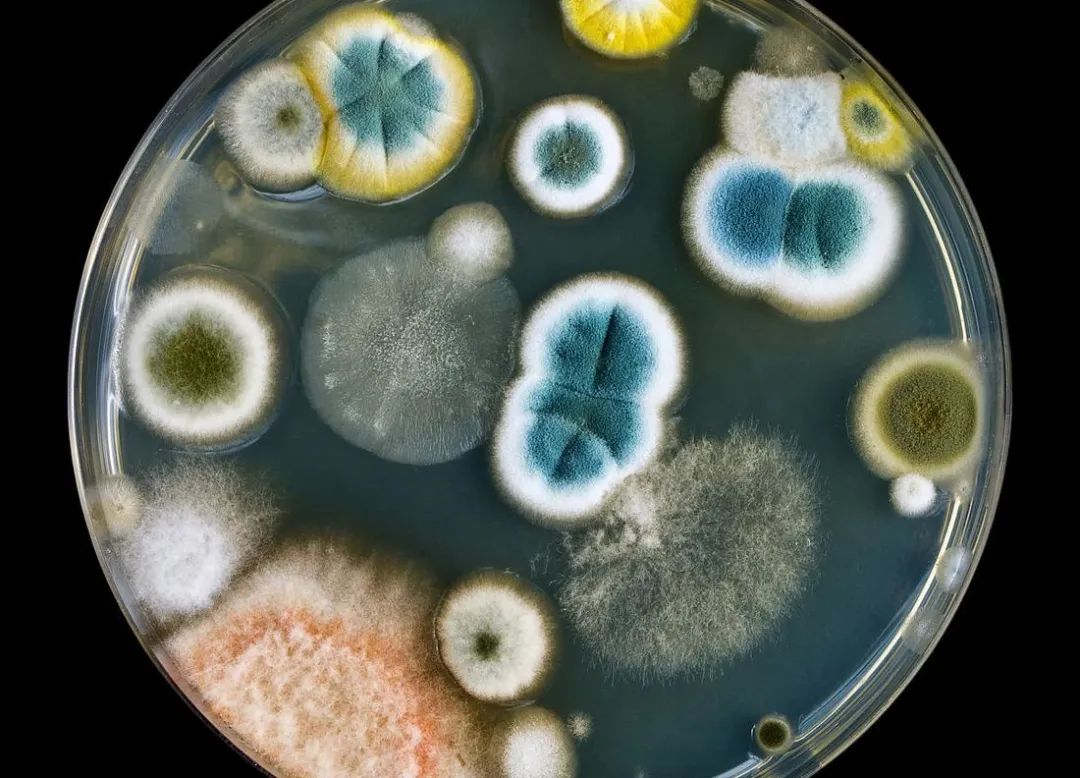
9927463b6231b45a10.jpg 9927463b6231b45a10.jpg

防潮防霉 无忧霉菌
来源:乐鱼网页版登录入口型材
作者: 时间:2023-01-05
点击量:1308
你以为的“霉”
单纯的附着在食品上或者物体上的菌落
实际上的“霉”
是霉变、霉菌向空气中挥发孢子……

霉雨天气,家里通风差
墙面受潮的老不干,玻璃总是蒙有一层雾气
长时间这样子发霉不说
湿度大了,住在里面的人容易疲劳乏力
四肢无力、没有食欲
在遇上令人头疼的回南天
最重要的就是防湿、除湿
想要彻底摆脱“霉”
除了勤通风之外
在源头上也要做一定的改变

在装修时
选择墙面装饰以及家具产品时
一定要选择防霉防潮的!
远离“隐形杀手” 现在开始防霉
密闭空间的霉菌对健康有非常大的伤害
霉菌释放的孢子会引发过敏等症状
有些毒性强的霉菌
更会引起严重的肺部病变甚至死亡!
乐鱼网页版登录入口1220实芯板-让你摆脱霉变
乐鱼网页版登录入口1220实芯板
是竹木纤维实心基材+热膜工艺耐磨膜层组成
零甲醛与TVOC的释放
还具有防污易洁、 防水防潮、抗弯耐用等性能
是品质与健康的双重保证






乐鱼网页版登录入口清逸板、珂雅板采用竹木纤维木塑发泡工艺、
1220实心大板采用竹木纤维实心发泡工艺,都拥有防潮防霉功效。
中国绿色建材产品认证
防潮防霉 环保无醛





